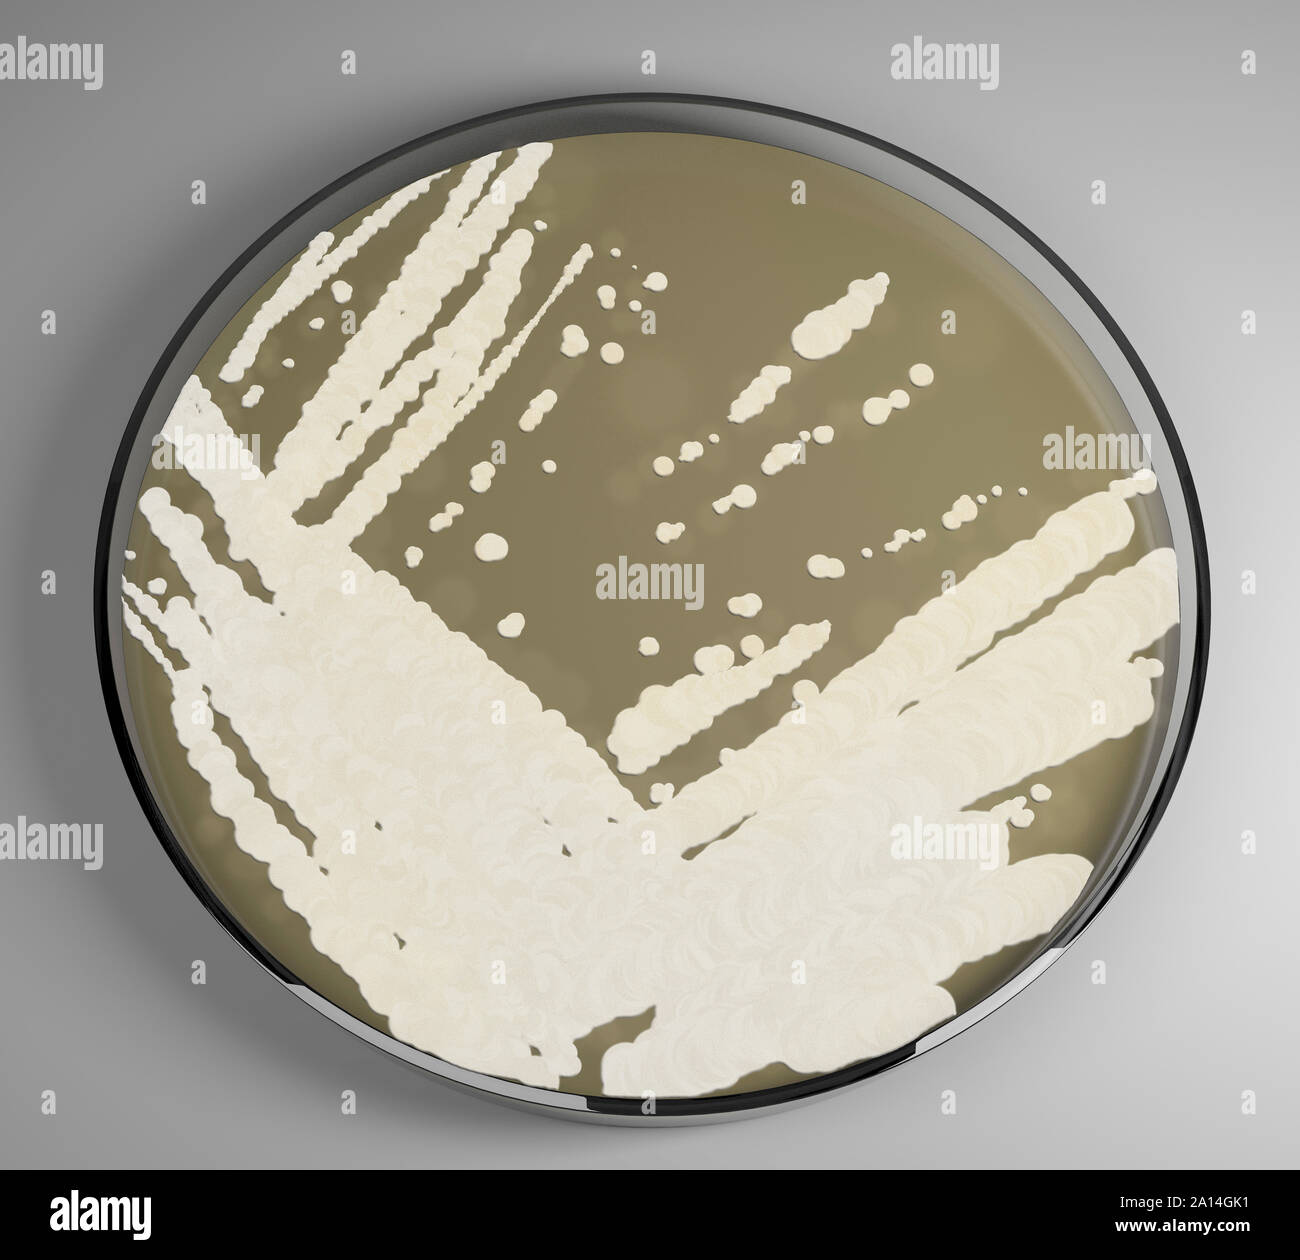

auris medical stock buy or sell
Whats Happening with EARS Stock Today. A B is better than a C.

The Virgin Mary Kawaii Clothes Kawaii Fashion Weird Fashion
Top Stocks to Buy in 2022.

. EARS stock joined the public market in July 2014 with an initial public offering. Auris was rallying 1863 to 382. Auris Medical Holding Ltd EARS stock is up 3767 while the SP 500 is unchanged 0 as of 935 AM on Tuesday Oct 13.
Auris Medical NASDAQEARS Price Target and Consensus Rating. Check if EARS Stock has a Buy or Sell Evaluation. An A is better than a B.
The company focuses currently on clinical-stage treatments. Hamilton bermuda july 6 2021 auris medical holding ltd. Smart Technology for Confident Trading.
EARS Stock Price NASDAQ Forecast Predictions Stock Analysis and Auris Medical Holding AG News. Real time Auris Medical Holding EARS stock price quote stock graph news analysis. So shareholders might well want to know whether insiders have been buying or selling shares in Auris Medical.
Percentage Held by Institutions. Auris Medical Holding employs 8 staff and has a trailing 12-month revenue of around 174475. Over the past year the SP 500 is up 1915 while EARS has fallen -4257.
Results are interpreted as buy sell or hold signals each with numeric ratings and summarized with an overall percentage buy or sell rating. Auris Medical Holding AG EARS Delayed Data from NSDQ 482 USD. Each analysts rating is normalized to a.
EARS is up 032 from the previous closing price of 084 on volume of 24608917 shares. The company is led. CytoDyn shares are on a two-day sell-off amid a.
Auris Medical was founded in 2003 and its headquarters is located in Hamilton HM 11 Bermuda. High volatility in Auris Medical Holding AG stock price on Thursday which ended trading at. His last video delivered huge winner was viewed over seven million times.
Ears a company dedicated to addressing unmet medical needs through rna therapeutics allergy and viral infection protection and inner ear therapeutics today announced the selection of mutant kras-driven colorectal cancer as the first therapeutic indication for its oligophore oligonucleotide. After each calculation the program assigns a Buy Sell or Hold value. We use our internally-built news screening methodology to estimate the value of Auris Medical based on different types of headlines from major news networks to social media.
Auris Medical Holding stocks EARSUS are listed on the NASDAQ and all prices are listed in US Dollars. Auris Medical Holding is a biotechnology business based in the US. Ad Learn about Fisher Wallace Laboratories.
MarketBeat calculates consensus analyst ratings for stocks using the most recent rating from each Wall Street analyst that has rated a stock within the last twelve months. The event calendar will help you understand the most critical current and past headlines together with many other corporate. Only 603 of the stock of Auris Medical is held by institutions.
That means you want to buy stocks with a Zacks Rank 1 or 2 Strong Buy or Buy which. How MarketBeat Calculates Price Target and Consensus Rating. To buy or sell any stock and does not take account of your objectives or your.
CytoDyns Chief Medical Officer Departs. This would suggest that Auris Medical Holdings shares are more volatile than the average for this exchange and represent relatively-speaking a higher risk but potentially also market-beating returns. Of course Auris Medical Holding may not be the best stock to buy.
For long-term investors stocks are a good investment even during periods of the market volatility - a stock market downturn means that many stocks are on sale. And a D is better than an F. The company had planned to move it to the clinics in the first quarter.
Its last market close was 319 the same closing value as a week prior. Ad Viral stock-picking sensation Adam ODell releases video detailing 1 stock pick of 2022. Ad Get 200 in stock as a new tastyworks customer when you fund with 2000.
This is unsurprising given that its market capitalization is just 37 million. Ad With Best-in-Class Trading Tools No Hidden Fees Trading Anywhere Else Would be Settling. Award-winning customer service - were there when you need us.
A C is better than a D. Backed By 30 Years Of Experience. Auris Medical Holding overview.
So you may wish to see this free collection of companies boasting high return on equity or this list of stocks that insiders are. Auris Medical stocks price quote with latest real-time prices charts financials latest news technical analysis and opinions. It is a matter of debate whether stock price prediction based on information in financial news can generate a strong buy or sell signal.
Invest in the future of mental healthcare. Do Not Sell My Personal Information. As an investor you want to buy stocks with the highest probability of success.
Ad Explore the Latest Features Tools to Become a More Strategic Trader. Investing in stocks such as Auris Medical is an excellent way to grow wealth. In the past three months Auris Medical insiders have not sold or bought any company stock.
The market NASDAQ average beta is 1 while Auris Medical Holdings is 14048. Auris Medical typically flies under the radar.

Drug Resistant Superbug Thriving In Hospitals Already Hit Hard By Covid 19

Auris Surgical Robotics Closes 80m Hansen Medical Buy Massdevice

Auris Medical Holding Stock Forecast Down To 2 382 Usd Ears Stock Price Prediction Long Term Short Term Share Revenue Prognosis With Smart Technical Analysis

Here S Why We Worry About Auris Medical Holding S Nasdaq Ears Cash Burn Situation

Historical Ears Stock Prices Quote Auris Medical Holding Ag

Auris Medical Holding Ltd 2020 Q2 Results Earnings Call Presentation Nasdaq Cyto Seeking Alpha

Auris Surgical Robotics Closes 80m Hansen Medical Buy Massdevice

Pin On Refillable Pod Systems Aio Kits
3d Model Of Candida Auris Growing In A Petri Dish Stock Photo Alamy

Auris Medical Crunchbase Company Profile Funding

Auris Medical Holding Ltd 2020 Q2 Results Earnings Call Presentation Nasdaq Cyto Seeking Alpha

Auris Medical Pivots From Hearing Loss Drugs Joins Red Hot Rna Therapies Field Medcity News

Auris Medical Price Target Analyst Ratings Nasdaq Ears

Ears Stock 7 Things For Auris Medical Investors To Know As Shares Continue To Soar Nasdaq

Auris Medical Holding Stock Forecast Down To 2 382 Usd Ears Stock Price Prediction Long Term Short Term Share Revenue Prognosis With Smart Technical Analysis

Auris Medical Holding Ltd 2020 Q2 Results Earnings Call Presentation Nasdaq Cyto Seeking Alpha
/candida-auris-4692475_FINAL-776ad17888c4420eb7bb3f0ff821591f.jpg)
Candida Auris Symptoms Causes Diagnosis Treatment

Auris Medical Holding Ltd 2020 Q2 Results Earnings Call Presentation Nasdaq Cyto Seeking Alpha

Buy Or Sell Auris Health Inc Stock Pre Ipo Via An Equityzen Fund Equityzen